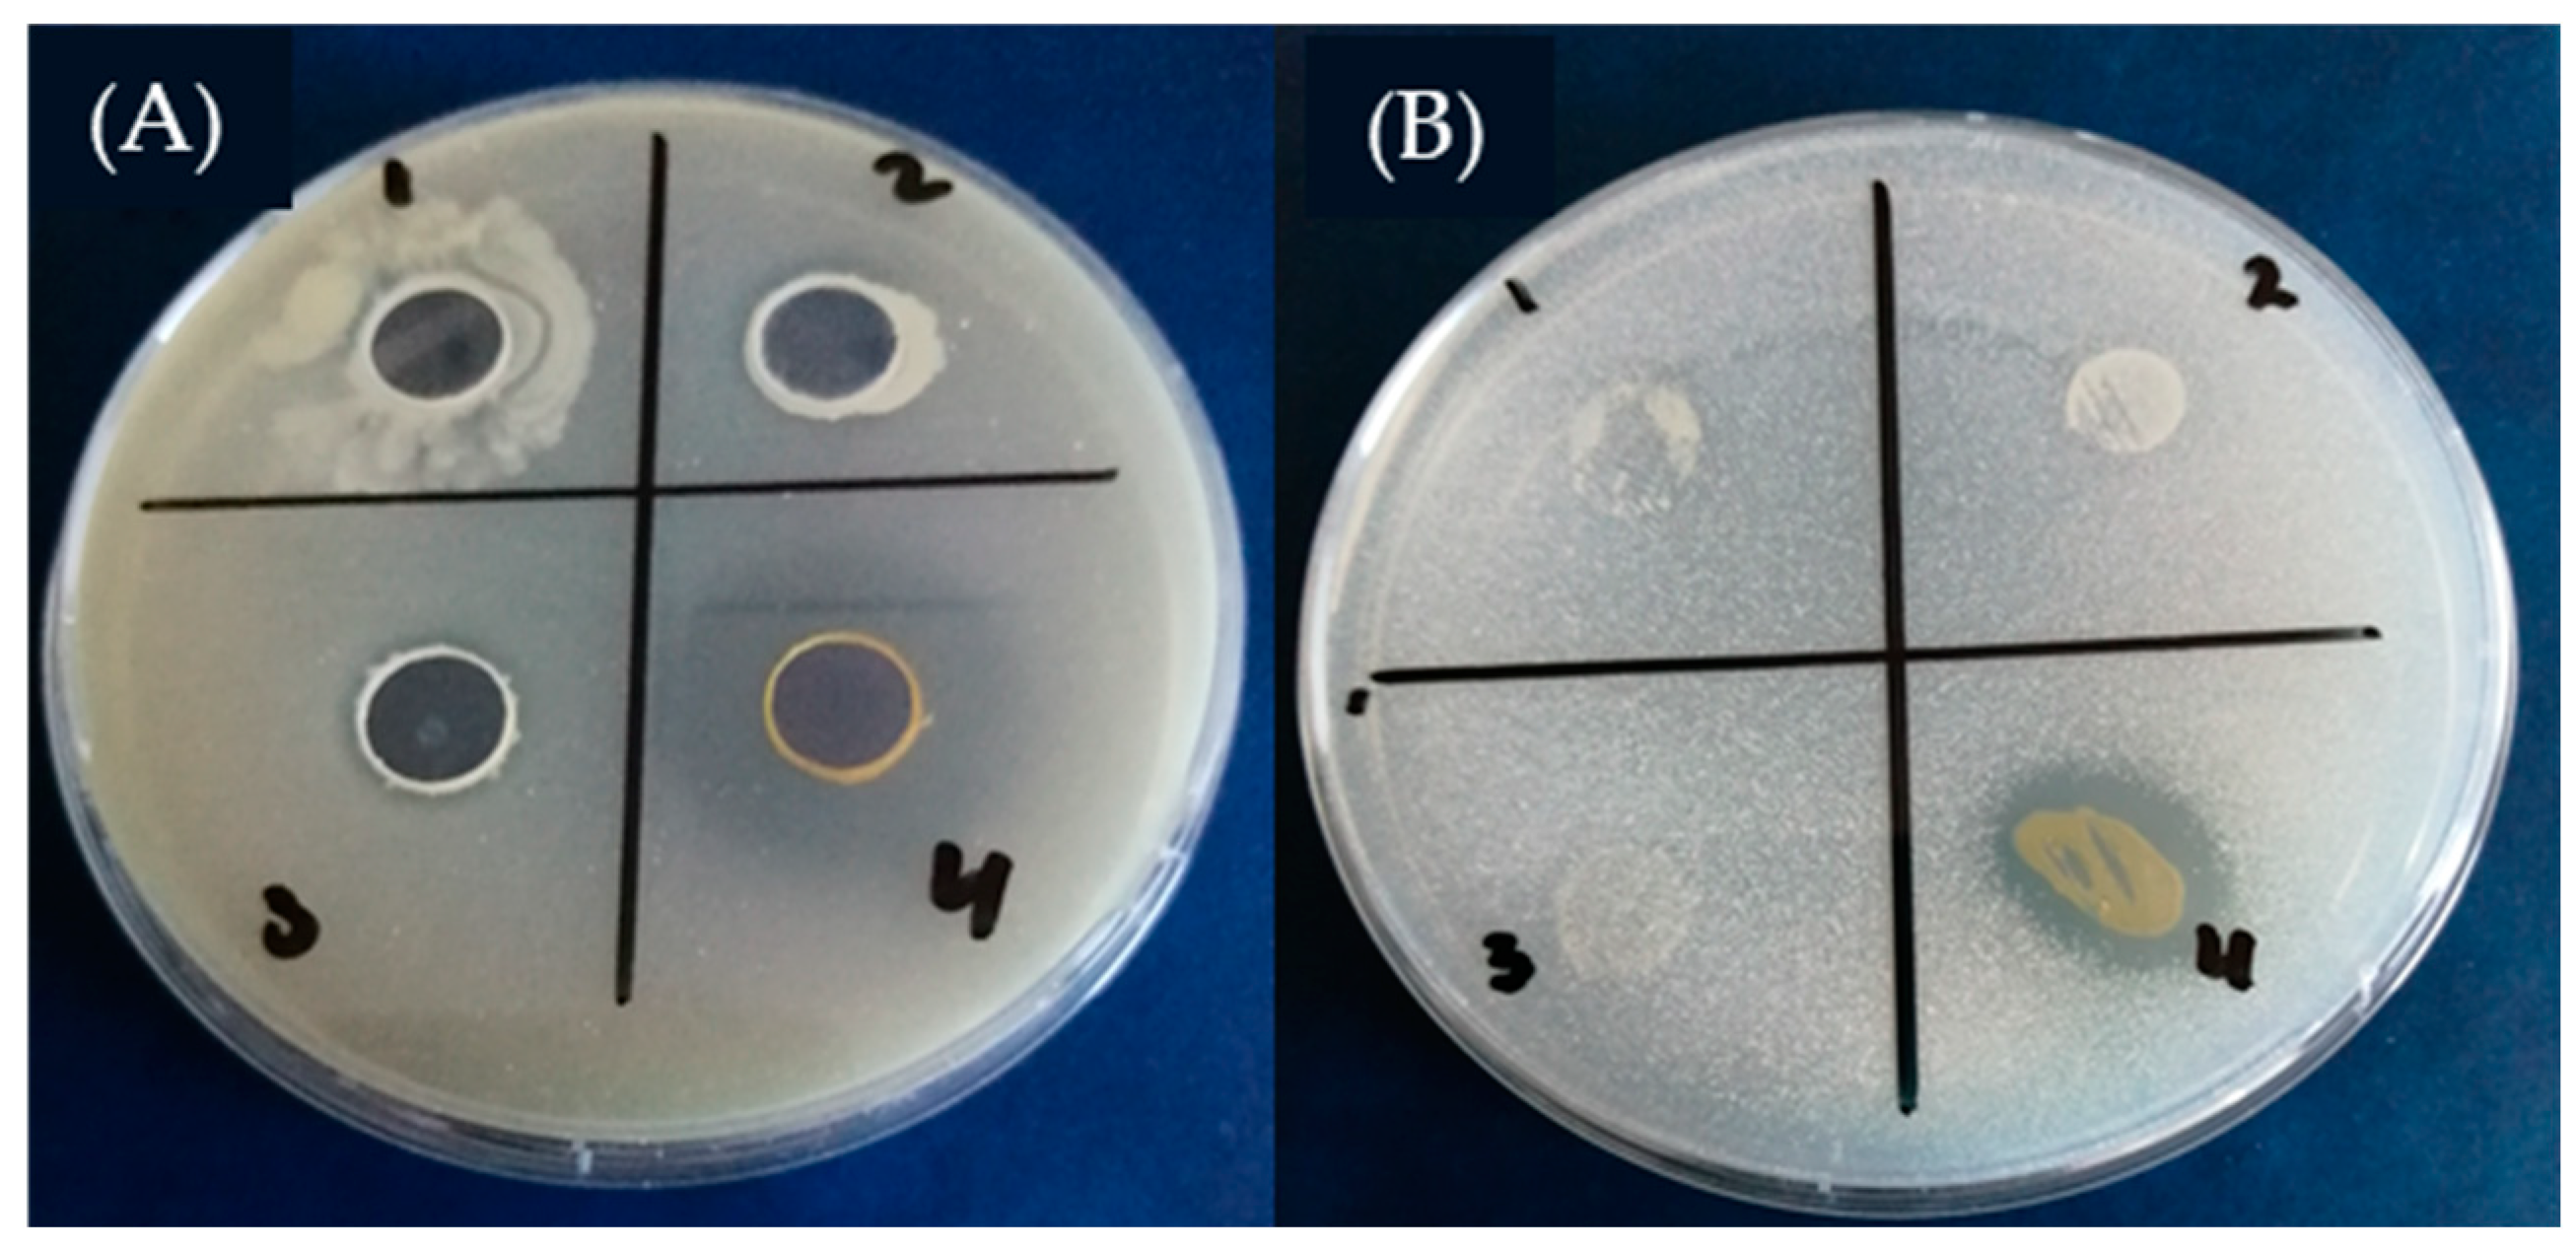
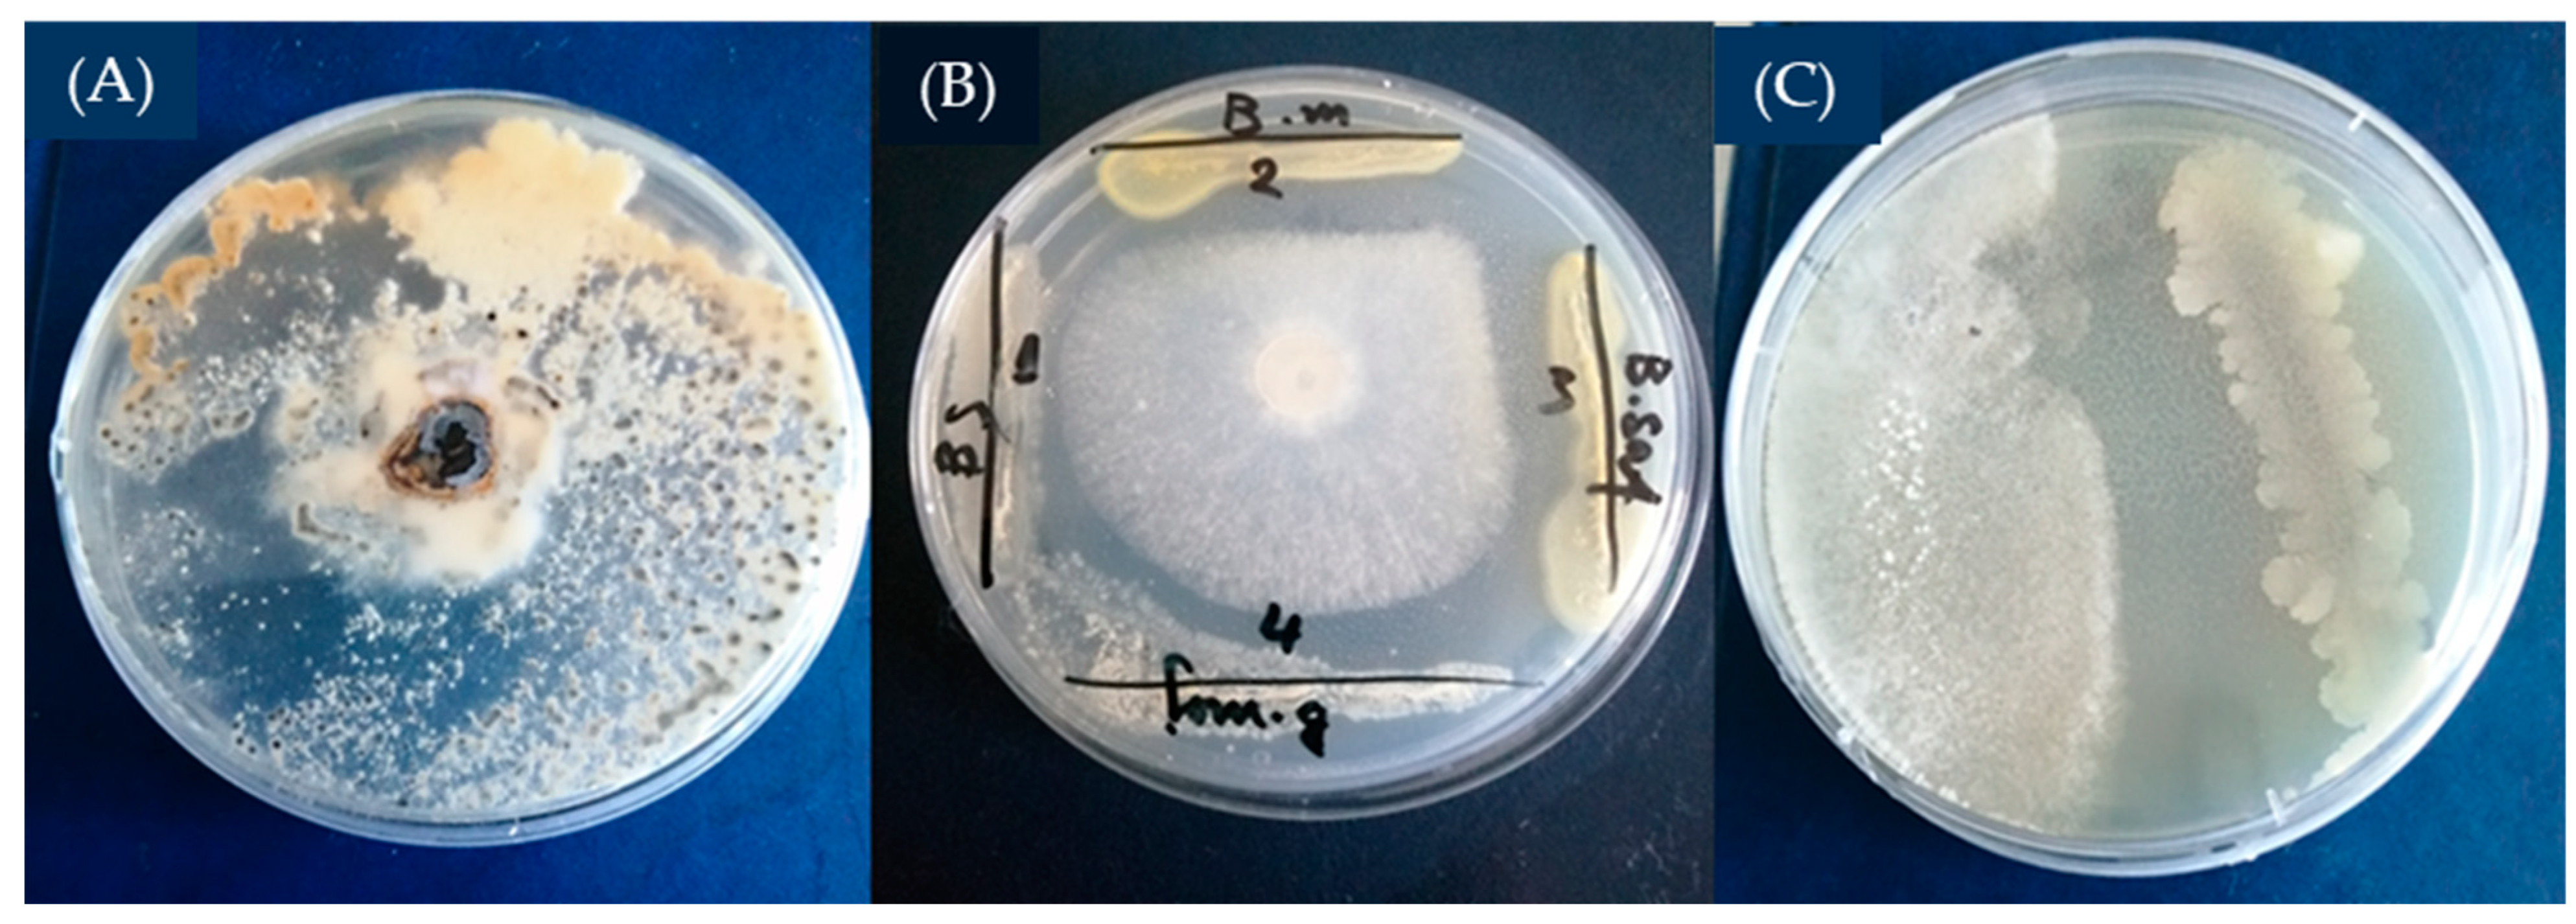

Biological Control of Lettuce Drop (Sclerotinia minor Jagger) Using Antagonistic Bacillus Species
Abstract
1. Introduction
2. Materials and Methods
2.1. Bacteria
2.2. Amylolytic Activity of Tested Bacillus Strains
2.3. Proteolytic Activity of Bacillus Strains
3. Quantification of the Synthesized Secondary Metabolites with Phytohormonal Activity
3.1. Quantification of Indole-3-Acetic Acid Using the Salkowski Reagent
3.2. Screening for Dissolution of Inorganic Phosphates
3.3. ZnO Dissolution Screening
4. Antimicrobial Activity against Sclerotinia minor
4.1. Screening for the Production of Siderophores
4.2. Dual Culture Assay for the Screening of Biocontrol of Syderophore-Produsing B. mojavensis
4.3. Isolation of Sclerotinia minor Pathogen and Antimicrobial Activity against Sclerotinia minor
5. Results and Discussion
5.1. Selection of the Isolated Bacillus Strains According to Their Amylolytic Activity
5.2. Study of Proteolytic Activity of Tested Bacillus sp.
5.3. Quantification of Indole-3-Acetic Acid (IAA)
5.4. Screening for Dissolution of Inorganic Phosphate and ZnO
5.5. The Production of Siderophores
5.6. In Vitro Antifungal Activity of the Tested Bacillus Strains
Author Contributions
Funding
Data Availability Statement
Acknowledgments
Conflicts of Interest
References
- Hao, J.J.; Subbarao, K.V.; Duniway, J.M. Germination of Sclerotinia minor and S. sclerotiorum sclerotia under various soil moisture and temperature combinations. Phytopathology 2003, 93, 443–450. [Google Scholar] [CrossRef] [PubMed]
- Abawi, G.S.; Robinson, R.W.; Cobb, A.C.; Shail, J.W. Reaction of lettuce germ plasm to artificial inoculation with Sclerotinia minor under greenhouse conditions. Plant Dis. 1980, 64, 668–671. [Google Scholar] [CrossRef]
- Mamo, B.E.; Hayes, R.J.; Truco, M.J.; Puri, K.D.; Michelmore, R.W.; Subbarao, K.V.; Simko, I. The genetics of resistance to lettuce drop (Sclerotinia spp.) in lettuce in a recombinant inbred line population from Reine des Glaces × Eruption. Theor. Appl. Genet. 2019, 132, 2439–2460. [Google Scholar] [CrossRef]
- Whipps, J.M.; Budge, S.P.; McClement, S.; Pink, D.A. A glasshouse cropping method for screening lettuce lines for resistance to Sclerotinia sclerotiorum. Eur. J. Plant Pathol. 2002, 108, 373–378. [Google Scholar] [CrossRef]
- Foley, M.E.; Doğramacı, M.; West, M.; Underwood, W.R. Environmental factors for germination of Sclerotinia sclerotiorum sclerotia. J. Plant Pathol. Microbiol. 2016, 7, 379–383. [Google Scholar] [CrossRef]
- Grube, R.; Ryder, E. Identification of lettuce (Lactuca sativa L.) germplasm with genetic resistance to drop caused by Sclerotinia minor. J. Am. Soc. Hortic. Sci. 2004, 129, 70–76. [Google Scholar] [CrossRef]
- Imolehin, E.D.; Grogan, R.G.; Duniway, J.M. Effect of temperature and moisture tension on growth, sclerotial production, germination, and infection by Sclerotinia minor. Phytopathology 1980, 70, 1153–1157. [Google Scholar] [CrossRef]
- Subbarao, K.V. Progress toward integrated management of lettuce drop. Plant Dis. 1998, 82, 1068–1078. [Google Scholar] [CrossRef] [PubMed]
- Jones, E.E.; Stewart, A. Biological control of Sclerotinia minor in lettuce using Trichoderma species. Proc. N. Z. Plant Prot. Conf. 1997, 50, 154–158. [Google Scholar] [CrossRef]
- Del Rio, L.E.; Martinson, C.A.; Yang, X.B. Biological control of Sclerotinia stem rot of soybean with Sporidesmium sclerotivorum. Plant Dis. 2002, 86, 999–1004. [Google Scholar] [CrossRef]
- Partridge, D.E.; Sutton, T.B.; Jordan, D.L.; Curtis, V.L.; Bailey, J.E. Management of Sclerotinia blight of peanut with the biological control agent Coniothyrium minitans. Plant Dis. 2006, 90, 957–963. [Google Scholar] [CrossRef] [PubMed]
- Elias, L.M.; Domingues, M.V.P.; Moura, K.E.D.; Harakava, R.; Patricio, F.R.A. Selection of Trichoderma isolates for biological control of Sclerotinia minor and S. sclerotiorum in lettuce. Summa Phytopathol. 2016, 42, 216–221. [Google Scholar] [CrossRef]
- Barrière, V.; Lecompte, F.; Nicot, P.C.; Maisonneuve, B.; Tchamitchian, M.; Lescourret, F. Lettuce cropping with less pesticides. A review. Agron. Sustain. Dev. 2014, 34, 175–198. [Google Scholar] [CrossRef]
- Adams, P.B.; Wong, J.A.-L. The effect of chemical pesticides on the infection of sclerotia of Sclerotinia minor by the biocontrol agent Sporidesmium sclerotivorum. Phytopathology 1999, 181, 1340–1343. [Google Scholar]
- Larena, I.; Melgarejo, P. Biological Control of Monilinia laxa and Fusarium oxysporum f. sp. Lycopersici by a Lytic Enzyme-Producing Penicillium purpurogenum. Biol. Control 1996, 6, 361–367. [Google Scholar] [CrossRef]
- Crosa, J.H.; Walsh, C.T. Genetics and assembly line enzymology of siderophore biosynthesis in bacteria. Microbiol. Mol. Biol. Rev. 2002, 66, 223–249. [Google Scholar] [CrossRef]
- Gram, L. The influence of substrate on siderophore production by fish spoilage bacteria. J. Microbiol. Meth. 1996, 25, 199–205. [Google Scholar] [CrossRef]
- Kiyohara, H.; Nagao, K.; Yana, K. Rapid screen for bacteria degrading water-insoluble, solid hydrocarbons on agar plates. Appl. Environ. Microbiol. 1982, 43, 454–457. [Google Scholar] [CrossRef]
- Hu, Q.P.; Xu, J.G.; Song, P.; Song, J.N.; Chen, W.L. Isolation and identification of a potential biocontrol agent Bacillus subtilis QM3 from Qinghai yak dung in China. World J. Microbiol. Biotechnol. 2008, 24, 2451–2458. [Google Scholar] [CrossRef]
- Fernando, W.D.; Nakkeeran, S.; Zhang, Y. 13 Ecofriendly methods in combating Sclerotinia sclerotiorum (Lib.) de Bary. Recent Res. Dev. Environ. Biol. 2004, 1, 329–347. [Google Scholar]
- Saharan, G.S.; Mehta, N. Sclerotinia Diseases of Crop Plants: Biology, Ecology and Disease Management; Springer: Dordrecht, The Netherlands, 2008. [Google Scholar]
- Sabaté, D.C.; Brandan, C.P.; Petroselli, G.; Erra-Balsells, R.; Audisio, M.C. Biocontrol of Sclerotinia sclerotiorum (Lib.) de Bary on common bean by native lipopeptide-producer Bacillus strains. Microbiol. Res. 2018, 211, 21–30. [Google Scholar] [CrossRef] [PubMed]
- Alvarez, F.; Castro, M.; Príncipe, A.; Borioli, G.; Fischer, S.; Mori, G.; Jofré, E. The plant-associated Bacillus amyloliquefaciens strains MEP218 and ARP23 capable of producing the cyclic lipopeptides iturin or surfactin and fengycin are effective in biocontrol of sclerotinia stem rot disease. J. Appl. Microbiol. 2012, 112, 159–174. [Google Scholar] [CrossRef]
- Ribeiro, I.D.A.; Bach, E.; da Silva Moreira, F.; Müller, A.R.; Rangel, C.P.; Wilhelm, C.M.; Passaglia, L.M.P. Antifungal potential against Sclerotinia sclerotiorum (Lib.) de Bary and plant growth promoting abilities of Bacillus isolates from canola (Brassica napus L.) roots. Microbiol. Res. 2021, 248, 126754. [Google Scholar] [CrossRef] [PubMed]
- Kim, M.; Morrison, M.; Yu, Z. Evaluation of different partial 16S rRNA gene sequence regions for phylogenetic analysis of microbiomes. J. Microbiol. Methods 2011, 84, 81–87. [Google Scholar] [CrossRef]
- Agati, V.; Guyot, J.; Talamond, P.; Hounhouigan, D.; Morlon-Guyot, J. Isolation and characterization of new amylolytic strains of Lactobacillus fermentum from fermented maize doughs (mawè and ogi) from Benin. J. Appl. Microbiol. 1998, 85, 512–520. [Google Scholar] [CrossRef]
- Nabrdalik, M.; Grata, K.; Latała, A. Proteolytic activity of Bacillus cereus strains. Proc. ECOpole 2010, 4, 273–277. [Google Scholar]
- Petkova, M.; Stefanova, P.; Gotcheva, V.; Kuzmanova, I.; Angelov, A. Microbiological and physicochemical characterization of traditional Bulgarian sourdoughs and screening of lactic acid bacteria for amylolytic activity. J. Chem. Technol. Metall. 2020, 55, 921–934. [Google Scholar]
- Spaepen, S. Plant hormones produced by microbes. In Principles of Plant-Microbe Interactions: Microbes for Sustainable Agriculture; Springer International Publishing: Cham, Switzerland, 2014; pp. 247–256. [Google Scholar]
- Petkova, M.; Gotcheva, V.; Dimova, M.; Bartkiene, E.; Rocha, J.M.; Angelov, A. Screening of Lactiplantibacillus plantarum Strains from Sourdoughs for Biosuppression of Pseudomonas syringae pv. syringae and Botrytis cinerea in Table Grapes. Microorganisms 2022, 10, 2094. [Google Scholar] [CrossRef]
- Gordon, S.A.; Weber, R.P. Colorimetric estimation of indoleacetic acid. Plant Physiol. 1951, 26, 192. [Google Scholar] [CrossRef]
- Patil, V.S. Bacillus subtilis: A potential salt tolerant phosphate solubilizing bacterial agent. Int. J. Life Sci. Biotechnol. Pharma Res. 2014, 3, 141. [Google Scholar]
- Khande, R.; Sharma, S.K.; Ramesh, A.; Sharma, M.P. Zinc solubilizing Bacillus strains that modulate growth, yield and zinc biofortification of soybean and wheat. Rhizosphere 2017, 4, 126–138. [Google Scholar] [CrossRef]
- Ramesh, A.; Sharma, S.K.; Sharma, M.P.; Yadav, N.; Joshi, O.P. Inoculation of zinc solubilizing Bacillus aryabhattai strains for improved growth, mobilization and biofortification of zinc in soybean and wheat cultivated in Vertisols of central India. Appl. Soil Ecol. 2014, 73, 87–96. [Google Scholar] [CrossRef]
- Sakthivel, N.; Gnanamanickam, S.S. Toxicity of Pseudomonas fluorescens towards rice sheath-rot pathogen Acrocylindrium oryzae Saw. Curr. Sci. India 1986, 55, 106–107. [Google Scholar]
- Harwood, C.R.; Kikuchi, Y. The ins and outs of Bacillus proteases: Activities, functions and commercial significance. FEMS Microbiol. Rev. 2022, 46, fuab046. [Google Scholar] [CrossRef]
- Spaepen, S.; Vanderleyden, J. Auxin and plant-microbe interactions. Cold Spring Harb. Perspect. Biol. 2011, 3, a001438. [Google Scholar] [CrossRef] [PubMed]
- Thaler, P.; Pages, L. Modelling the influence of assimilate availability on root growth and architecture. Plant Soil 1998, 201, 307–320. [Google Scholar] [CrossRef]
- Klingshirn, C. ZnO: From basics towards applications. Phys. Status Solidi 2007, 244, 3027–3073. [Google Scholar] [CrossRef]
- Chen, T.; Liu, X.; Li, X.; Zhao, K.; Zhang, J.; Xu, J.; Dahlgren, R.A. Heavy metal sources identification and sampling uncertainty analysis in a field-scale vegetable soil of Hangzhou, China. Environ. Pollut. 2009, 157, 1003–1010. [Google Scholar] [CrossRef]
- Kushwaha, P.; Kashyap, P.L.; Bhardwaj, A.K.; Kuppusamy, P.; Srivastava, A.K.; Tiwari, R.K. Bacterial endophyte mediated plant tolerance to salinity: Growth responses and mechanisms of action. World J. Microbiol. Biotechnol. 2020, 36, 26. [Google Scholar] [CrossRef]
- Saleem, S.; Malik, A.; Khan, S.T. Prospects of ZnO-nanoparticles for Zn biofortification of Triticum aestivum in a zinc-solubilizing bacteria environment. J. Soil Sci. Plant Nutr. 2023, 23, 4350–4360. [Google Scholar] [CrossRef]
- De Los Santos-Villalobos, S. Burkholderia cepacia XXVI siderophore with biocontrol capacity against Colletotrichum gloeosporioides. World J. Microbiol. Biotechnol. 2012, 28, 2615–2623. [Google Scholar] [CrossRef] [PubMed]
- Mehri, I.; Khessairi, A.; Yousra, T.; Neila, S.; Imen, D.; Marie, M.J.; Abdennasseur, H. Effect of dose response of zinc and manganese on siderophores induction. Am. J. Environ. Sci. 2012, 8, 143–151. [Google Scholar]
- Ramos-Solano, B.; García, J.A.L.; Garcia-Villaraco, A.; Algar, E.; Garcia-Cristobal, J.; Mañero, F.J.G. Siderophore and chitinase producing isolates from the rhizosphere of Nicotiana glauca Graham enhance growth and induce systemic resistance in Solanum lycopersicum L. Plant Soil. 2010, 334, 189–197. [Google Scholar] [CrossRef]
- Peltier, A.J.; Bradley, C.A.; Chilvers, M.I.; Malvick, D.K.; Mueller, D.S.; Wise, K.A.; Esker, P.D. Biology, yield loss and control of Sclerotinia stem rot of soybean. J. Integr. Pest Manag. 2012, 3, B1–B7. [Google Scholar] [CrossRef]
- Garza, J.G.; Neumann, S.; Vyn, T.J.; Boland, G.J. Influence of crop rotation and tillage on production of apothecia by Sclerotinia sclerotiorum. Can. J. Plant Pathol. 2002, 24, 137–143. [Google Scholar] [CrossRef]
- Gulya, T.; Rashid, K.Y.; Masirevic, S.M. Sunflower Diseases. In Sunflower Technology and Production; Schneiter, A.A., Ed.; American Society of Agronomy, Crop Science Society of American, Soil Sience Society of America: Madison, WI, USA, 1997; pp. 263–379. [Google Scholar]
- Abdullah, M.T.; Ali, N.Y.; Suleman, P. Biological control of Sclerotinia sclerotiorum (Lib.) de Bary with Trichoderma harzianum and Bacillus amyloliquefaciens. Crop Prot. 2008, 27, 1354–1359. [Google Scholar] [CrossRef]
- Nandi, M.; Berry, C.; Brassinga, A.K.; Belmonte, M.F.; Fernando, W.G.; Loewen, P.C.; de Kievit, T.R. Pseudomonas brassicacearum strain DF41 kills Caenorhabditis elegans through biofilm-dependent and biofilm-independent mechanisms. Appl. Environ. Microbiol. 2016, 82, 6889–6898. [Google Scholar] [CrossRef]
- Berry, C.; Fernando, W.D.; Loewen, P.C.; De Kievit, T.R. Lipopeptides are essential for Pseudomonas sp. DF41 biocontrol of Sclerotinia sclerotiorum. Biol. Control 2010, 55, 211–218. [Google Scholar] [CrossRef]

| No | Bacillus Strain | Amilolytic Activity, mm | |
|---|---|---|---|
| Cultured Cells | Cell-Free Supernatant | ||
| 1 | Bacillus subtilis | 22.365 ± 1.983 a | 10.821 ± 0.938 a |
| 2 | Priestia megaterium | 22.166 ± 1.912 a | 11.052 ± 0.828 a |
| 3 | Bacillus safensis | 29.263 ± 1.1654 b* | 12.207 ± 0.725 b* |
| 4 | Bacillus mojavensis | 15.823 ±1.028 c* | 9.350 ± 0.813 a* |
| No | B. Strain | Proteolytic Activity, mm | |||||
|---|---|---|---|---|---|---|---|
| Cultured Cells | Cell-Free Supernatant | ||||||
| 24 h | 48 h | 72 h | 24 h | 48 h | 72 h | ||
| 1 | B. subtilis | 24.0 ± 0.206 a | 33.3 ± 0.162 a | 38.6 ± 0.561 *a | 0 | 13.0 ± 0.224 b* | 11.8 ± 0.321 a |
| 2 | P. megaterium | 25.5 ± 0.218 a | 38.9 ± 0.176 a | 40.6 ± 0.324 b | 0 | 6.08 ± 0.186 a | 12.6 ± 0.052 a |
| 3 | B. safensis | 32.2 ± 0.702 b* | 42.4 ± 0.275 b* | 48.2 ± 0.803 b* | 8.0 ± 0.15 | 12.5 ± 0.173 b | 16.3 ± 0.820 b* |
| 4 | B. mojavesis | 23.4 ± 0.369 a | 26.6 ± 0.294 a | 28.3 ± 0.193 a | 0 | 7.8 ± 0.204 a | 10.3 ± 0.563 a |
Disclaimer/Publisher’s Note: The statements, opinions and data contained in all publications are solely those of the individual author(s) and contributor(s) and not of MDPI and/or the editor(s). MDPI and/or the editor(s) disclaim responsibility for any injury to people or property resulting from any ideas, methods, instructions or products referred to in the content. |
© 2024 by the authors. Licensee MDPI, Basel, Switzerland. This article is an open access article distributed under the terms and conditions of the Creative Commons Attribution (CC BY) license (https://creativecommons.org/licenses/by/4.0/).
Share and Cite
Petkova, M.; Dimova, M. Biological Control of Lettuce Drop (Sclerotinia minor Jagger) Using Antagonistic Bacillus Species. Appl. Microbiol. 2024, 4, 1283-1293. https://doi.org/10.3390/applmicrobiol4030088
Petkova M, Dimova M. Biological Control of Lettuce Drop (Sclerotinia minor Jagger) Using Antagonistic Bacillus Species. Applied Microbiology. 2024; 4(3):1283-1293. https://doi.org/10.3390/applmicrobiol4030088
Chicago/Turabian StylePetkova, Mariana, and Milena Dimova. 2024. "Biological Control of Lettuce Drop (Sclerotinia minor Jagger) Using Antagonistic Bacillus Species" Applied Microbiology 4, no. 3: 1283-1293. https://doi.org/10.3390/applmicrobiol4030088
APA StylePetkova, M., & Dimova, M. (2024). Biological Control of Lettuce Drop (Sclerotinia minor Jagger) Using Antagonistic Bacillus Species. Applied Microbiology, 4(3), 1283-1293. https://doi.org/10.3390/applmicrobiol4030088

